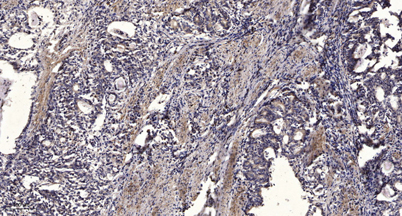

IRX5 rabbit pAb
 One-click to copy product information
One-click to copy product information$148.00/50µL $248.00/100µL
| 50 µL | $148.00 |
| 100 µL | $248.00 |
Overview
| Product name: | IRX5 rabbit pAb |
| Reactivity: | Human; Mouse |
| Source: | Rabbit |
| Dilutions: | WB 1:500-2000;IHC-p 1:50-300 |
| Immunogen: | Synthesized peptide derived from human IRX5 AA range: 64-114 |
| Storage: | -20°C/1 year |
| Clonality: | Polyclonal |
| Isotype: | IgG |
| Concentration: | 1 mg/ml |
| Molecular Weight: | 53kD |
| GeneID: | 10265 |
| Human Swiss-Prot No: | P78411 |
| Cellular localization: | Nucleus . |
| Background: | This gene encodes a member of the iroquois homeobox gene family, which are involved in several embryonic developmental processes. Knockout mice lacking this gene show that it is required for retinal cone bipolar cell differentiation, and that it negatively regulates potassium channel gene expression in the heart to ensure coordinated cardiac repolarization. Alternatively spliced transcript variants encoding different isoforms have been found for this gene. [provided by RefSeq, Nov 2011], |
-
 Western blot analysis of lysates from 3T3 cells, primary antibody was diluted at 1:1000, 4°over night
Western blot analysis of lysates from 3T3 cells, primary antibody was diluted at 1:1000, 4°over night -
Immunohistochemical analysis of paraffin-embedded human Gastric adenocarcinoma. 1, Antibody was diluted at 1:200(4° overnight). 2, Tris-EDTA,pH9.0 was used for antigen retrieval. 3,Secondary antibody was diluted at 1:200(room temperature, 45min).
Immunohistochemical analysis of paraffin-embedded human Gastric adenocarcinoma. 1, Antibody was diluted at 1:200(4° overnight). 2, Tris-EDTA,pH9.0 was used for antigen retrieval. 3,Secondary antibody was diluted at 1:200(room temperature, 45min).

 Manual
Manual